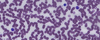
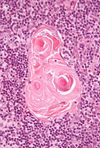

Histologi COPY Flashcards
(27 cards)
Vad visar bilden?

Hud
Epidermis – olika celltyper:
Keratinocyter, melanocyter. Kan vara pigmenterat
Stratum basale, stratum spinosum, stratum granulosum, stratum lucidum (endast tjock hud), stratum corneum
Dermis
Stratum papillare och stratum reticulare
Hårfolliklar, talgkörtlar, svettkörtlar – eccrina och apokrina
Känselkroppar: Meissners korpuskel och Vater-Pacinis korpuskel
Subcutis/hypodermis
Fettvävnad, körtelvävnad

Vad visar bilden?

Hud
Epidermis – olika celltyper:
Keratinocyter, melanocyter. Kan vara pigmenterat
Stratum basale, stratum spinosum, stratum granulosum, stratum lucidum (endast tjock hud), stratum corneum
Dermis
Stratum papillare och stratum reticulare
Hårfolliklar, talgkörtlar, svettkörtlar – eccrina och apokrina
Känselkroppar: Meissners korpuskel och Vater-Pacinis korpuskel
Subcutis/hypodermis
Fettvävnad, körtelvävnad

Vad visar bilden?

Vater-pacinis korpuskel
- Synliga med blotta ögat vid kirurgi
- I djupa dermis och subcutis
Vad visar bilden?

Meissners korpuskel
Finns oftast strax under epidermis och på platser där vi behöver finkänslighet, typ handen
Hur ser du skillnad på keratinocyt och melanocyt?

Varför är de mest basala keratinocyterna ofta bruna?

Vad visar bilden?

Tjock hud (finns på sulor, handflata)
Har inga hårfolliklar eller talgkörtlar
Epidermis – olika celltyper:
Keratinocyter, melanocyter. Kan vara pigmenterat
Stratum basale, stratum spinosum, stratum granulosum, stratum lucidum (endast tjock hud), stratum corneum
Dermis
Stratum papillare och stratum reticulare
Svettkörtlar – eccrina och apokrina
Känselkroppar: Meissners korpuskel och Vater-Pacinis korpuskel
Subcutis/hypodermis
Fettvävnad, körtelvävnad

Vad visar bilden?

Hårfollikel
Vad visar bilden?
Var finns bara den ena av dem?

Eccrina körtlar överst
Apocrina körtlar (större) underst som bara finns axillart, skrev, mamillae och analt (ofta i närheten av hår)
Vad visar bilden?

Hårfollikel med tillhörande talgkörtel (på kanterna till follikeln)
Vad visar bilden?

Lymfkörtel

Bindvävskapsel som skickar in trabekler. Hilus. Medulla och cortex
Lymffolliklar i cortex med germinalcentra (ljusare struktur i mitten av bollarna) och mantelzon
Subkapsulära sinus (utrymmet mellan kapsel och kortex), trabekulära sinus (invaginationerna) och medullära sinus (går till märgen där de mörka strukturerna är lymfocyter med mindre cytoplasma)
Vad visar bilden?

Lymfkörtel

Bindvävskapsel som skickar in trabekler. Hilus (det som går in på kanten). Medulla och cortex
Lymffolliklar i cortex med germinalcentra (ljusare struktur i mitten av bollarna) och mantelzon
Subkapsulära sinus (utrymmet mellan kapsel och kortex), trabekulära sinus (invaginationerna) och medullära sinus (går till märgen där de mörka strukturerna är lymfocyter med mindre cytoplasma)
Vad visar bilden?

Tonsill
Semiinkapslade organ: kapsel inåt och stratifierat, infiltrerat skivepitel ut mot munhåla
Bindvävssepta från kapseln. Epitel bildar kryptor
Lymffolliklar, primära och sekundära. Germinalcentra och mantelzon. HEV.

ATT IDENTIFIERA Erytrocyter, trombocyter och leukocyter (neutrofila granulocyter, eosinofila granulocyter, basofila granulocyter, monocyter, lymfocyter)
Kolla på kärnans utseende, förhållande mellan kärna och cytoplasma
Lymfocyten lite cytoplasma (ingen skillnad på T och B), troligen en lymfocyt på bilden
Leukocyter har flest neutrofiler (så finns det många är det oftast dessa) på bilden är det troligen neutrofiler med den klassiska multilobulära kärnan

Vad visar bilden?

Basofil granulocyt
Vad visar bilden?

Eosina granulocyter
Vad visar bilden?

Neutrofila granulocyter (vilket det oftast är)
Vad visar bilden?

Mjälte
Bindvävskapsel, trabekler (fibrös vävnad i mjälten) med trabekulära artärer och vener, mjältsträngar
Röd (mellan lymffolliklarna) och vit pulpa (lymffolliklar med germinalcentra, centralartär)
PALS – periarterial lymphatic sheat

Vad visar bilden?

Thymus

Bindvävskapsel, bildar trabekler och delar in organet i lobuli. Cortex som är T-lymfocyter (runt de vita strukturerna) och medulla som också är T-lymfocyter men inte lika tätt (kontinuerlig i hela organet)
Epitelioretikulära celler (färre, lite större och ljusare), thymocyter. Hassalska kroppar. HEV.
Vad visar bilden?

Thymus
Bindvävskapsel, bildar trabekler och delar in organet i lobuli. Cortex och medulla (kontinuerlig i hela organet)
Epitelioretikulära celler, thymocyter. Hassalska kroppar. HEV.

Vad kallas de lite större och ljusare cellerna i Thymus?

Epitelioretikulära celler (färre, lite större och ljusare)
I vilket organ finns denna struktur och vad heter strukturen?

Finns i thymus specifikt
Hassalska kroppar
Vad kallas dessa runda strukturer för?

Vater-Pacini korpuskel

Vad visar bilden?

Mjälte
Bindvävskapsel, trabekler (fibrös vävnad i mjälten) med trabekulära artärer och vener, mjältsträngar
Röd (mellan lymffolliklarna) och vit pulpa (lymffolliklar med germinalcentra), centralartär
PALS – periarterial lymphatic sheat (omger centralartär på vissa bilder)





